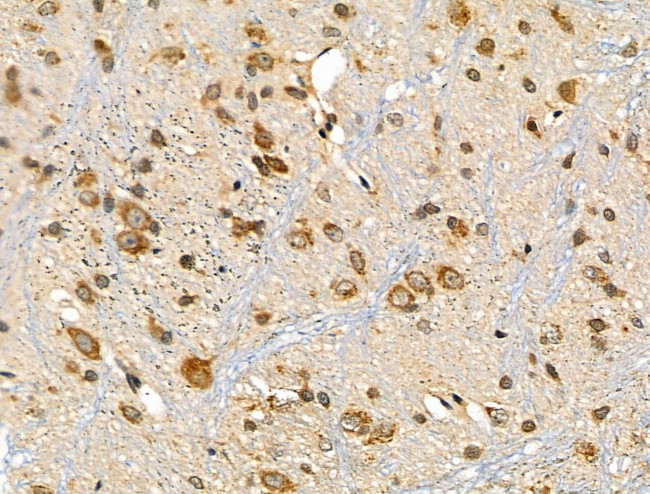
ARHGEF7 Antibody in Immunohistochemistry (Paraffin) (IHC (P))

Search
Invitrogen
ARHGEF7 Polyclonal Antibody
{{$productOrderCtrl.translations['antibody.pdp.commerceCard.promotion.promotions']}}
{{$productOrderCtrl.translations['antibody.pdp.commerceCard.promotion.viewpromo']}}
{{$productOrderCtrl.translations['antibody.pdp.commerceCard.promotion.promocode']}}: {{promo.promoCode}} {{promo.promoTitle}} {{promo.promoDescription}}. {{$productOrderCtrl.translations['antibody.pdp.commerceCard.promotion.learnmore']}}
图: 1 / 4
ARHGEF7 Antibody (PA5-101849) in IHC (P)




Please note: We are reviewing Western blot images included in the antibody testing data in our catalog, including those provided by third parties. Unless expressly labeled or annotated as “raw-unedited”, Western blot images included in the antibody testing data in our catalog may have been edited, optimized or otherwise adjusted for presentation.
产品信息
PA5-101849
种属反应
宿主/亚型
分类
类型
抗原
偶联物
形式
浓度
规格
纯化类型
保存液
内含物
保存条件
运输条件
RRID
产品详细信息
Antibody detects endogenous levels of total ARHGEF7.
靶标信息
The serine/threonine kinase, p21 activated kinase (PAK), is a downstream effector of the small GTPases Cdc42 and Rac. PAK associates with Nck, the p85 and p110 subunits of PI3-kinase and PIX (PAK-interacting exchange factor) in a focal complex. The binding of PIX is necessary for the localization and activation of PAK in the Cdc42 to Rac signaling pathway, and this binding occurs through the high affinity of the N-terminal SH3 domain of PIX for a conserved proline rich PAK sequence. PIX exists as two isoforms, alpha and beta, and both are highly expressed in heart, muscle and thymus tissues of human and rat. alphaPIX is phosphorylated via PDGF and EphB2 receptor signaling pathways or through association with PI3-kinase. The alphaPIX isoform predominantly acts as a guanine nucleotide exchange factor (GEF) on Rac, which may mediate lamellipodia formation.
仅用于科研。不用于诊断过程。未经明确授权不得转售。
篇参考文献 (0)
生物信息学
蛋白别名: ARHGEF7; Beta-Pix; COOL-1; KIAA0142; p85; p85SPR; PAK-interacting exchange factor beta; Pak3 binding protein; PIXbeta; Rho guanine nucleotide exchange factor (GEF) 7; Rho guanine nucleotide exchange factor 7; SH3 domain-containing proline-rich protein; unnamed protein product
基因别名: ARHGEF7; BETA-PIX; betaPix; betaPix-b; betaPix-c; Cool; COOL-1; COOL1; KIAA0142; mKIAA0142; Nbla10314; P50; P50BP; P85; P85COOL1; P85SPR; PAK3; PAK3BP; PIX; PIXB
UniProt ID: (Rat) O55043, (Mouse) Q9ES28
Entrez Gene ID: (Human) 8874, (Rat) 114559, (Mouse) 54126